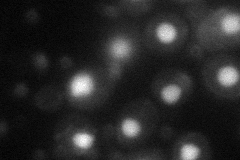
YKL114C
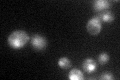
YKL114C

View description
Major apurinic/apyrimidinic endonuclease, 3'-repair diesterase involved in repair of DNA damage by oxidation and alkylating agents; also functions as a 3'-5' exonuclease to repair 7,8-dihydro-8-oxodeoxyguanosine
Localization:
Intensity:
Fold change:
Significance:
-
C’ GFP library in SD

nucleus26.54 -
N' NOP1pr-GFP in SD

nucleus,nucleolus190.82 -
N' TEF2pr-mCherry in SD

nucleus,nucleolus45.8986 -
N' NATIVEpr-GFP in SD

nucleus28.1445 -
N' TEF2pr-VC and Cyto-VN in SD
nucleus47.0953 -
C’ GFP library in SD+DTT

nucleus31.971.2No -
C’ GFP library in SD+H2O2

nucleus32.541.22No -
C’ GFP library in Starvation Media
nucleus45.291.7Yes -
C’ GFP library on the background of Pup2-DaMP

nucleus -
C’ GFP library on the background of CCT mutant

nucleus27.99491.05446No
